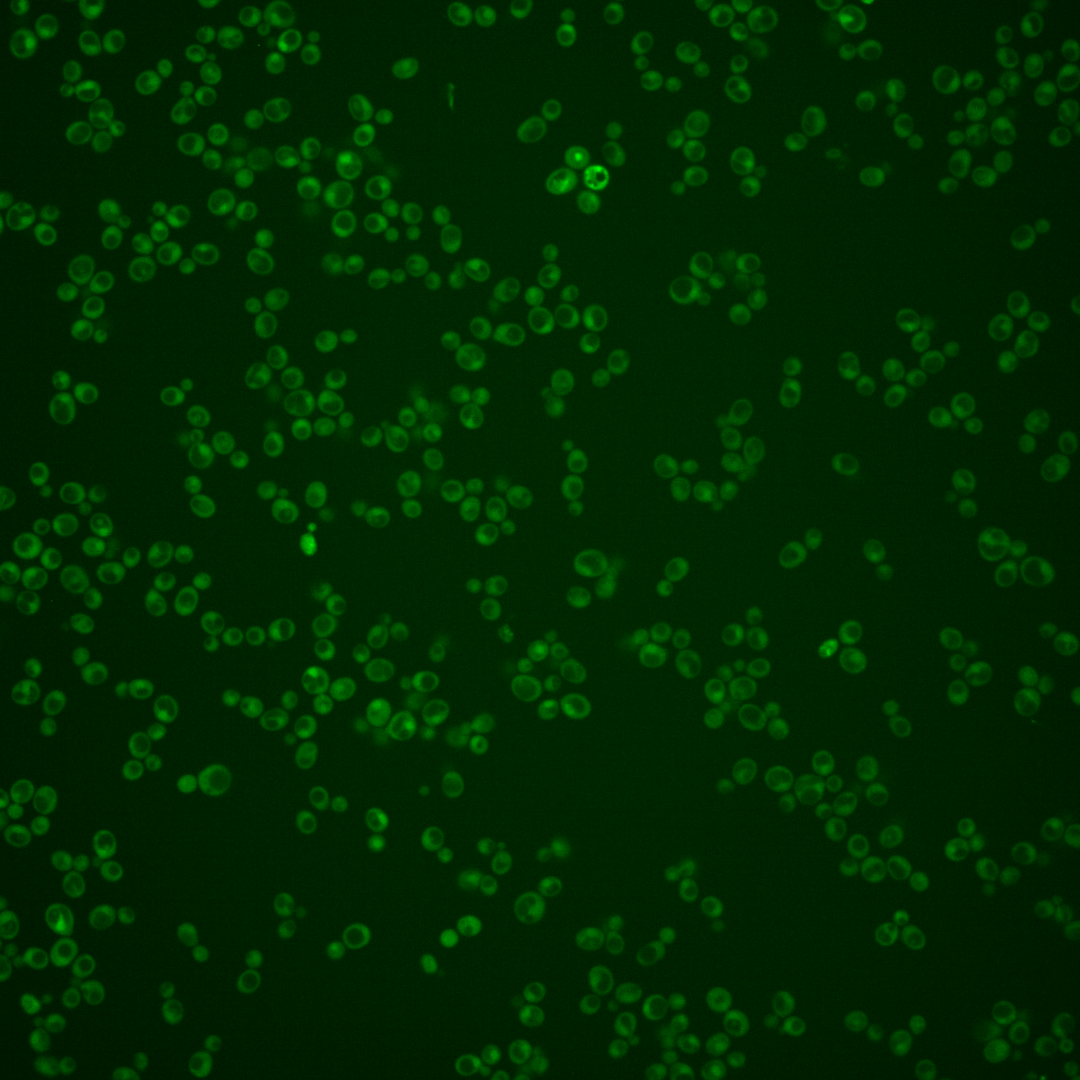
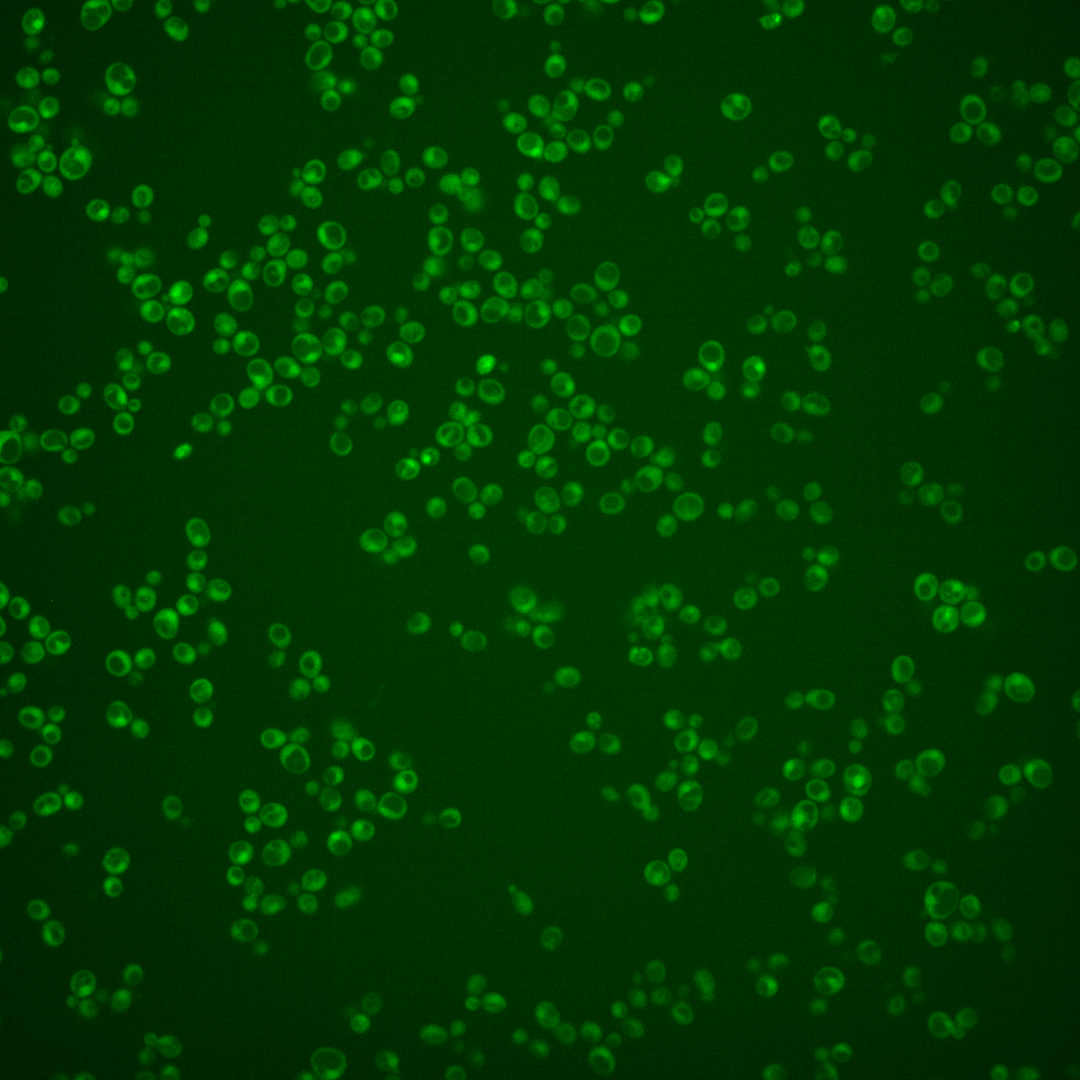
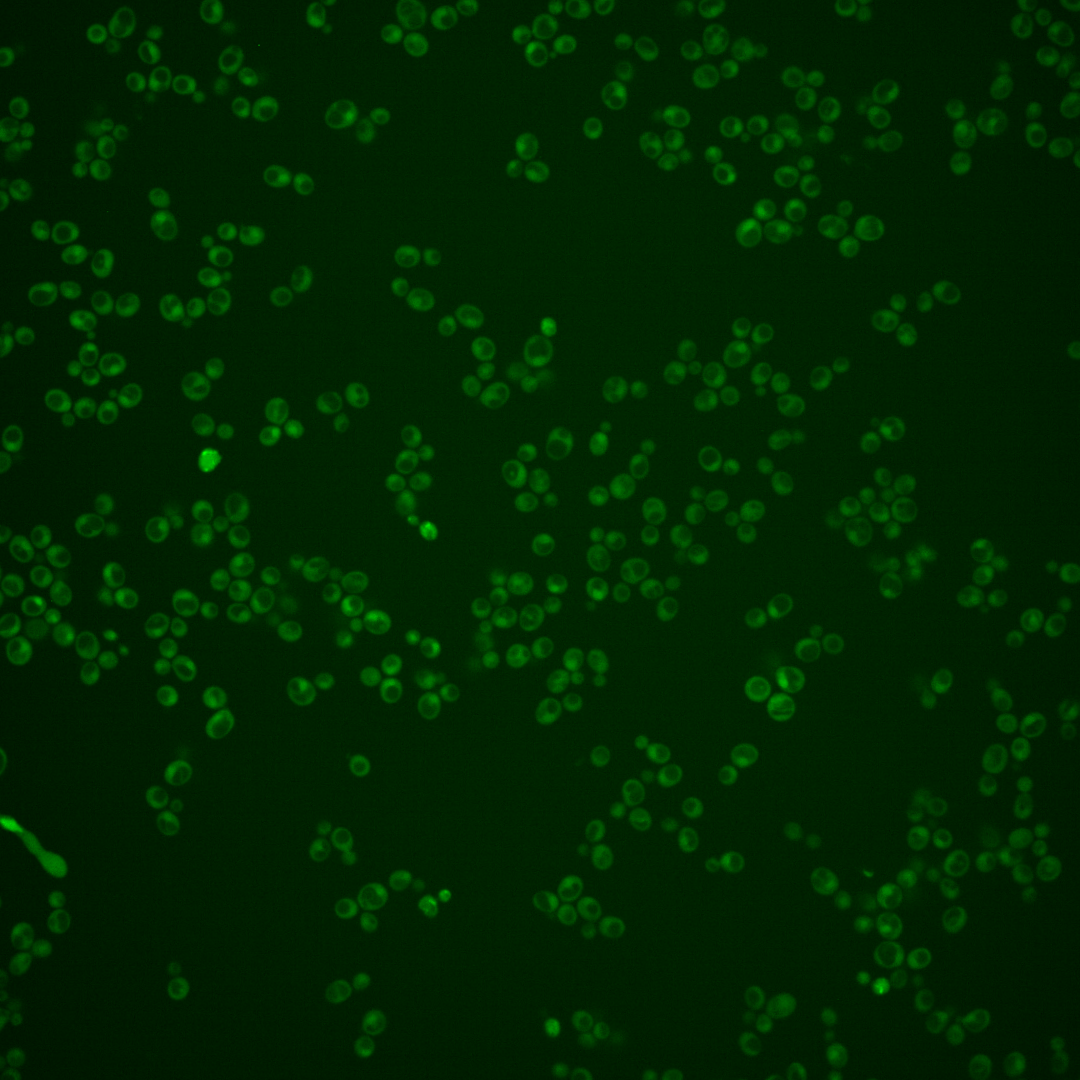
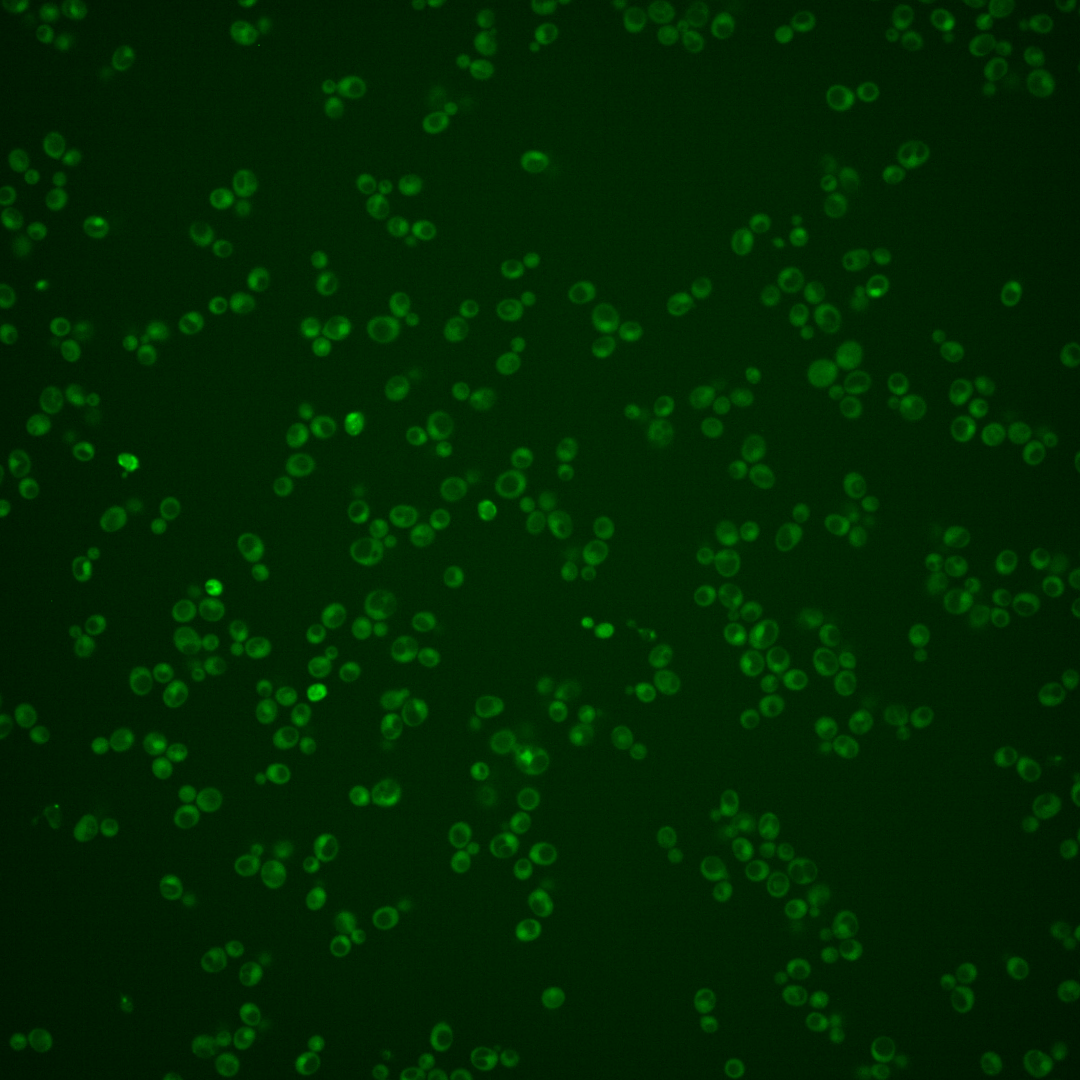
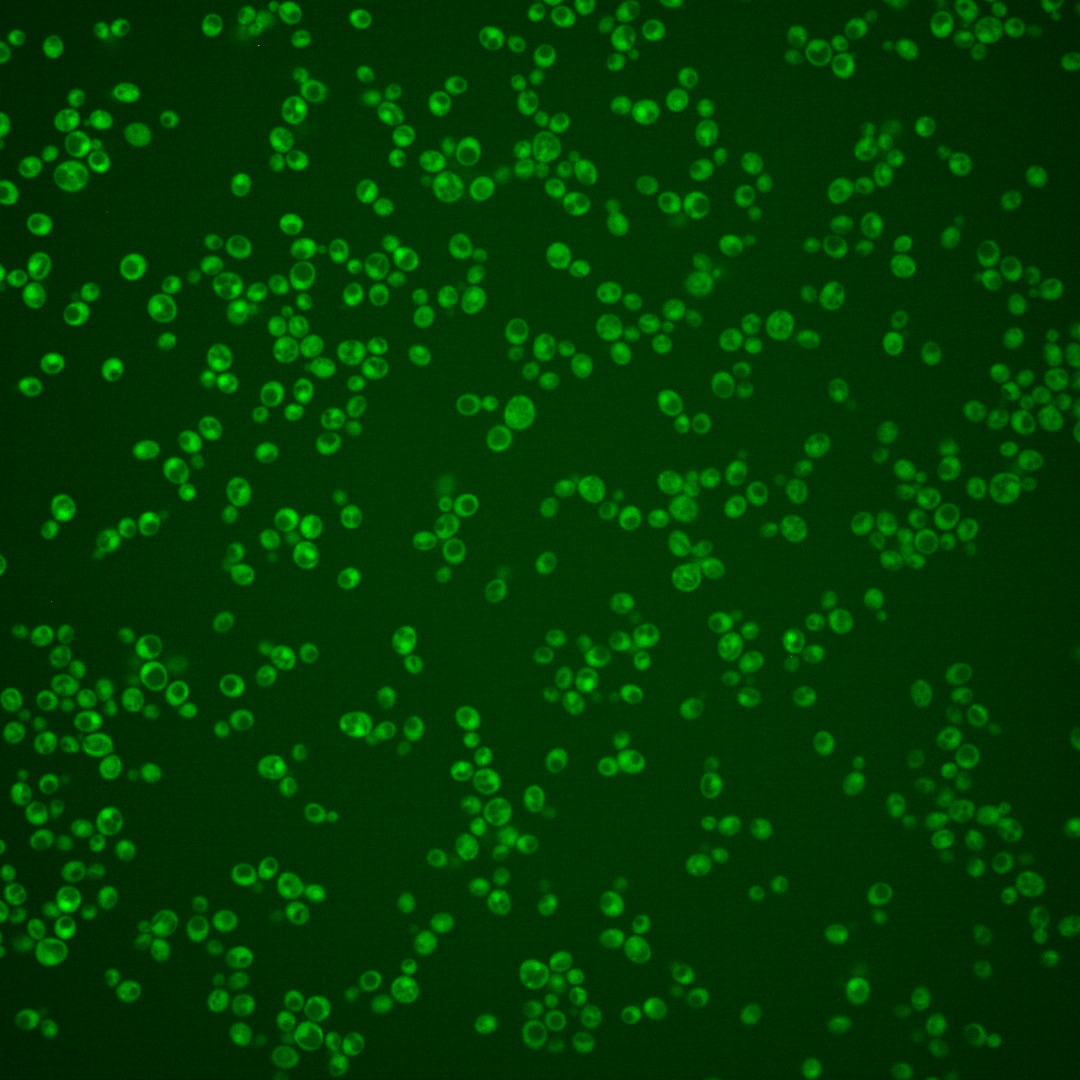
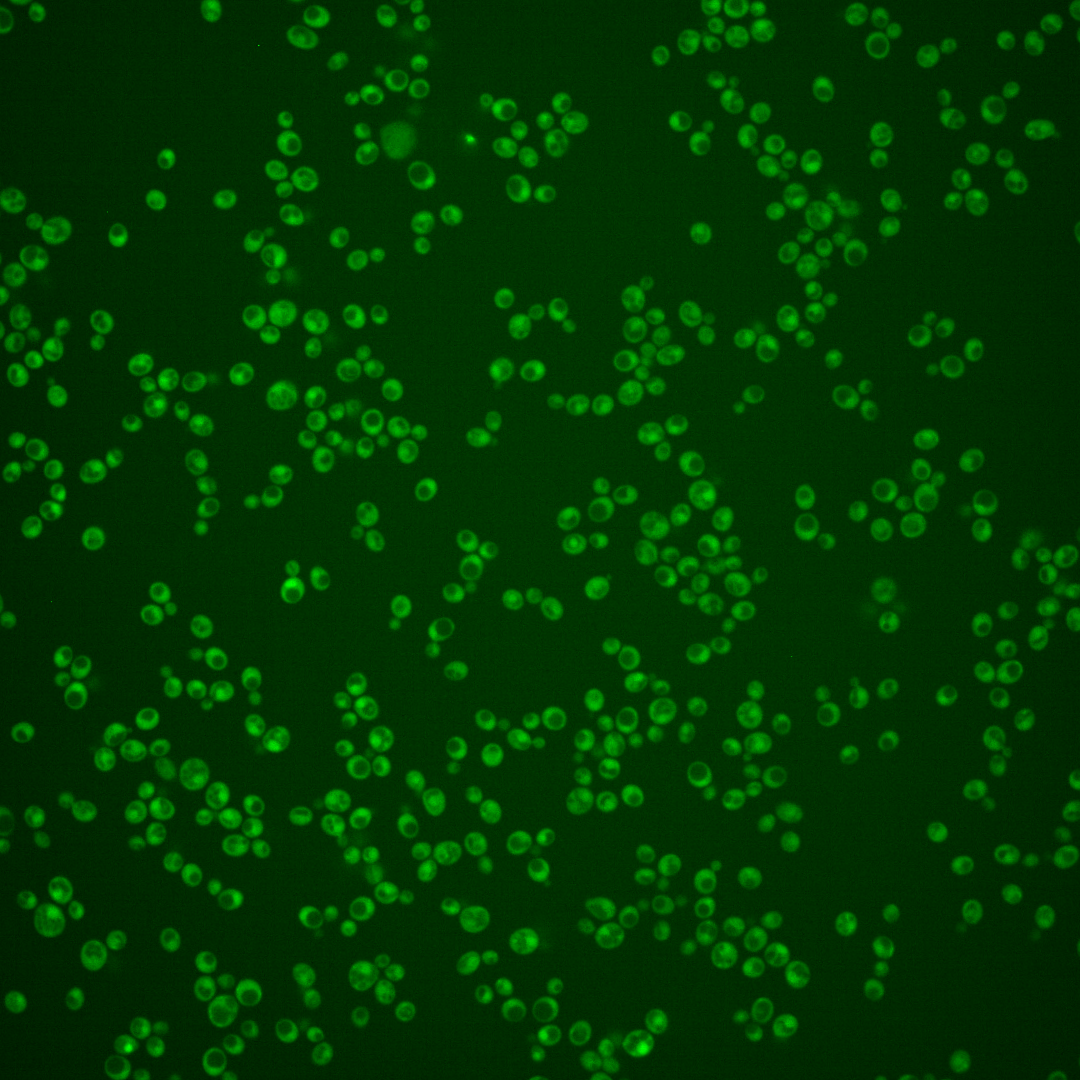
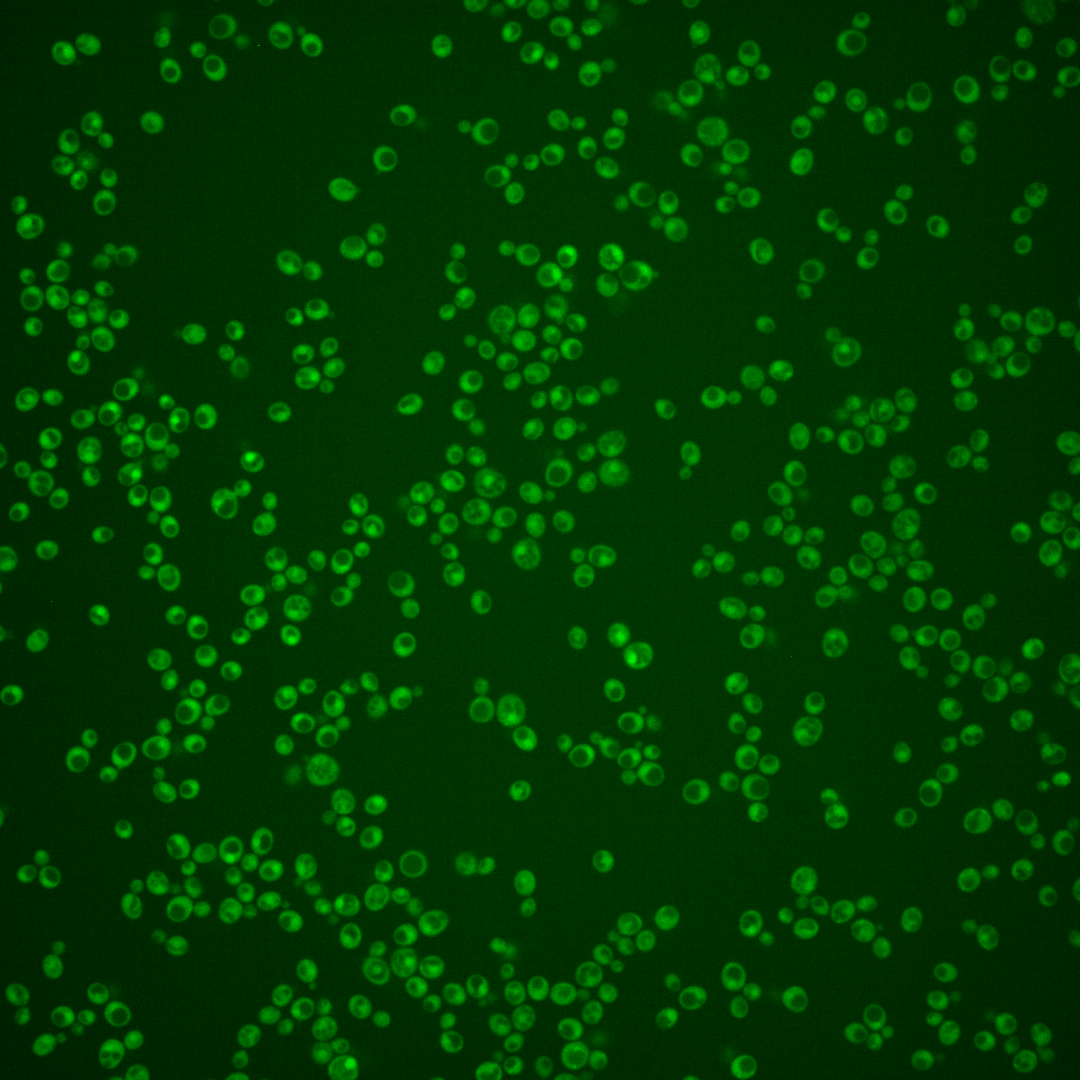

| Standard name | |
|---|---|
| Human Ortholog | |
| Description | Constitutively expressed acid phosphatase similar to Pho5p; brought to the cell surface by transport vesicles; hydrolyzes thiamin phosphates in the periplasmic space, increasing cellular thiamin uptake; expression is repressed by thiamin |
Micrographs




















































































Sub-cellular Localization
Yeast GFP Assignment
Protein Abundance
Localization Change
External localization resources
| ensLOC | DeepLoc | |||||||||||||||||||||||
|---|---|---|---|---|---|---|---|---|---|---|---|---|---|---|---|---|---|---|---|---|---|---|---|---|
| Localization | WT1 | WT2 | WT3 | RAP60 | RAP140 | RAP220 | RAP300 | RAP380 | RAP460 | RAP540 | RAP620 | RAP700 | HU80 | HU120 | HU160 | rpd3Δ_1 | rpd3Δ_2 | rpd3Δ_3 | WT1 | WT2 | WT3 | AF100 | AF140 | AF180 |
| Cortical Patches | 0 | 0 | 1 | 0 | 0 | 0 | 0 | 0 | 0 | 1 | 0 | 0 | 0 | 0 | 0 | 0 | 0 | 0 | 1 | 3 | 3 | 3 | 6 | 8 |
| Bud | 0 | 0 | 5 | 1 | 6 | 2 | 6 | 15 | 10 | 10 | 10 | 11 | 0 | 1 | 0 | 0 | 0 | 0 | 0 | 0 | 2 | 7 | 16 | 16 |
| Bud Neck | 0 | 0 | 1 | 1 | 1 | 1 | 1 | 10 | 5 | 2 | 0 | 2 | 0 | 0 | 0 | 1 | 0 | 1 | 0 | 0 | 0 | 2 | 2 | 7 |
| Bud Site | 0 | 0 | 0 | 0 | 0 | 1 | 2 | 0 | 2 | 2 | 1 | 1 | 0 | 0 | 0 | 0 | 0 | 0 | – | – | – | – | – | – |
| Cell Periphery | 0 | 1 | 0 | 1 | 1 | 2 | 2 | 0 | 0 | 0 | 0 | 1 | 1 | 2 | 0 | 0 | 1 | 1 | 0 | 0 | 1 | 2 | 4 | 5 |
| Cytoplasm | 45 | 194 | 169 | 190 | 246 | 271 | 285 | 421 | 217 | 237 | 121 | 180 | 387 | 820 | 765 | 409 | 228 | 237 | 67 | 154 | 117 | 222 | 419 | 321 |
| Endoplasmic Reticulum | 0 | 2 | 0 | 2 | 0 | 0 | 0 | 1 | 1 | 1 | 3 | 0 | 0 | 2 | 2 | 37 | 12 | 10 | 3 | 1 | 2 | 2 | 5 | 1 |
| Endosome | 0 | 0 | 0 | 0 | 1 | 0 | 0 | 2 | 0 | 0 | 0 | 0 | 0 | 0 | 1 | 8 | 3 | 3 | 1 | 3 | 1 | 0 | 6 | 3 |
| Golgi | 0 | 0 | 2 | 1 | 1 | 0 | 0 | 1 | 0 | 0 | 0 | 0 | 0 | 1 | 0 | 1 | 1 | 1 | 0 | 1 | 1 | 0 | 4 | 3 |
| Mitochondria | 11 | 5 | 11 | 17 | 21 | 129 | 159 | 185 | 156 | 191 | 179 | 234 | 0 | 1 | 0 | 12 | 0 | 0 | 12 | 22 | 39 | 18 | 31 | 28 |
| Nucleus | 0 | 1 | 0 | 1 | 0 | 1 | 1 | 2 | 2 | 2 | 1 | 0 | 1 | 0 | 1 | 0 | 0 | 2 | 0 | 0 | 0 | 0 | 0 | 0 |
| Nuclear Periphery | 0 | 1 | 0 | 1 | 1 | 0 | 0 | 0 | 0 | 1 | 0 | 0 | 0 | 0 | 0 | 0 | 0 | 0 | 0 | 0 | 0 | 0 | 1 | 1 |
| Nucleolus | 0 | 0 | 1 | 0 | 1 | 2 | 1 | 3 | 0 | 0 | 0 | 0 | 0 | 0 | 0 | 0 | 2 | 0 | 0 | 0 | 0 | 0 | 1 | 0 |
| Peroxisomes | 0 | 0 | 0 | 0 | 0 | 1 | 1 | 0 | 0 | 0 | 0 | 0 | 0 | 2 | 1 | 0 | 0 | 0 | 0 | 0 | 1 | 0 | 0 | 2 |
| SpindlePole | 0 | 0 | 1 | 0 | 1 | 5 | 13 | 21 | 9 | 5 | 5 | 7 | 0 | 0 | 0 | 0 | 0 | 0 | 1 | 1 | 2 | 3 | 10 | 9 |
| Vac/Vac Membrane | 0 | 1 | 2 | 0 | 3 | 1 | 4 | 2 | 1 | 2 | 2 | 5 | 0 | 1 | 1 | 61 | 71 | 36 | 2 | 4 | 3 | 24 | 53 | 37 |
| Unique Cell Count | 46 | 201 | 182 | 198 | 264 | 345 | 400 | 541 | 315 | 348 | 261 | 353 | 388 | 828 | 770 | 452 | 266 | 263 | 94 | 199 | 183 | 294 | 574 | 460 |
| Labelled Cell Count | 56 | 205 | 193 | 215 | 283 | 416 | 475 | 663 | 403 | 454 | 322 | 441 | 389 | 830 | 771 | 529 | 318 | 291 | 94 | 199 | 183 | 294 | 574 | 460 |
Yeast GFP Assignment
Protein Abundance
| Screen | WT1 | WT2 | WT3 | RAP60 | RAP140 | RAP220 | RAP300 | RAP380 | RAP460 | RAP540 | RAP620 | RAP700 | HU80 | HU120 | HU160 | rpd3Δ_1 | rpd3Δ_2 | rpd3Δ_3 | AF100 | AF140 | AF180 |
|---|---|---|---|---|---|---|---|---|---|---|---|---|---|---|---|---|---|---|---|---|---|
| Mean Cell GFP Intensity (1e-4) | 3.2 | 3.8 | 3.5 | 3.4 | 3.7 | 2.9 | 2.6 | 2.9 | 2.7 | 2.6 | 2.6 | 2.4 | 3.9 | 4.0 | 4.1 | 4.9 | 5.9 | 5.6 | 3.8 | 4.3 | 4.8 |
| Std Deviation (1e-4) | 0.5 | 1.0 | 1.4 | 1.4 | 2.1 | 1.1 | 1.1 | 1.0 | 1.1 | 1.6 | 0.9 | 1.1 | 1.3 | 1.4 | 1.5 | 1.2 | 1.5 | 1.2 | 1.1 | 1.9 | 2.0 |
| Intensity Change (Log2) | – | – | – | -0.03 | 0.08 | -0.28 | -0.41 | -0.27 | -0.36 | -0.45 | -0.45 | -0.53 | 0.16 | 0.18 | 0.22 | 0.5 | 0.75 | 0.69 | 0.13 | 0.29 | 0.46 |
Localization Change
| Localization | RAP60 | RAP140 | RAP220 | RAP300 | RAP380 | RAP460 | RAP540 | RAP620 | RAP700 | HU80 | HU120 | HU160 | rpd3Δ_1 | rpd3Δ_2 | rpd3Δ_3 |
|---|---|---|---|---|---|---|---|---|---|---|---|---|---|---|---|
| Actin | – | – | – | – | – | – | – | – | – | – | – | – | – | – | – |
| Bud | – | – | – | – | – | – | – | – | – | – | – | – | 0 | 0 | 0 |
| Bud Neck | – | – | – | – | – | – | – | – | – | – | – | – | 0 | 0 | 0 |
| Bud Site | – | – | – | – | – | – | – | – | – | – | – | – | 0 | 0 | 0 |
| Cell Periphery | – | – | – | – | – | – | – | – | – | – | – | – | 0 | 0 | 0 |
| Cyto | – | – | – | – | – | – | – | – | – | – | – | – | – | – | – |
| Endoplasmic Reticulum | – | – | – | – | – | – | – | – | – | – | – | – | 0 | 0 | 0 |
| Endosome | – | – | – | – | – | – | – | – | – | – | – | – | 0 | 0 | 0 |
| Golgi | – | – | – | – | – | – | – | – | – | – | – | – | 0 | 0 | 0 |
| Mitochondria | – | – | – | – | – | – | – | – | – | – | – | – | 0 | 0 | 0 |
| Nuclear Periphery | – | – | – | – | – | – | – | – | – | – | – | – | 0 | 0 | 0 |
| Nuc | – | – | – | – | – | – | – | – | – | – | – | – | – | – | – |
| Nucleolus | – | – | – | – | – | – | – | – | – | – | – | – | 0 | 0 | 0 |
| Peroxisomes | – | – | – | – | – | – | – | – | – | – | – | – | 0 | 0 | 0 |
| SpindlePole | – | – | – | – | – | – | – | – | – | – | – | – | 0 | 0 | 0 |
| Vac | – | – | – | – | – | – | – | – | – | – | – | – | – | – | – |
| Cortical Patches | – | – | – | – | – | – | – | – | – | – | – | – | 0 | 0 | 0 |
| Cytoplasm | – | – | – | – | – | – | – | – | – | – | – | – | 0 | 0 | 0 |
| Nucleus | – | – | – | – | – | – | – | – | – | – | – | – | 0 | 0 | 0 |
| Vacuole | – | – | – | – | – | – | – | – | – | – | – | – | 4.7 | 7.2 | 4.7 |
External localization resources
Images






























Protein Concentration and Protein Localization Data
| R1 | R2 | R3 | ||||||||||||||||
|---|---|---|---|---|---|---|---|---|---|---|---|---|---|---|---|---|---|---|
| G1 Pre-START | G1 Post-START | S/G2 | Metaphase | Anaphase | Telophase | G1 Pre-START | G1 Post-START | S/G2 | Metaphase | Anaphase | Telophase | G1 Pre-START | G1 Post-START | S/G2 | Metaphase | Anaphase | Telophase | |
| Concentration | -1.9677 | -1.1532 | -1.602 | -1.7596 | -1.9393 | -1.4173 | 0.8915 | 1.015 | 1.1961 | 0.59 | 1.1089 | 1.1264 | 1.1417 | 2.0008 | 1.7199 | 1.1129 | 1.4298 | 1.9172 |
| Actin | 0.0059 | 0.0019 | 0.0027 | 0.0002 | 0.0003 | 0.0011 | 0.0271 | 0.0003 | 0.0329 | 0.0358 | 0.0169 | 0.0042 | 0.0264 | 0.0001 | 0.0256 | 0.0011 | 0.0003 | 0.0305 |
| Bud | 0.0036 | 0.0003 | 0.0011 | 0 | 0 | 0.0018 | 0.0013 | 0.0008 | 0.0018 | 0.0027 | 0.0019 | 0.0007 | 0.0003 | 0.0003 | 0.0002 | 0.0023 | 0.0014 | 0.0007 |
| Bud Neck | 0.0023 | 0.0001 | 0.0003 | 0.0001 | 0 | 0.0074 | 0.0016 | 0.0018 | 0.0012 | 0.0002 | 0.001 | 0.0017 | 0.0012 | 0.0002 | 0.0005 | 0.0004 | 0.0076 | 0.001 |
| Bud Periphery | 0.0013 | 0.0006 | 0.0011 | 0.0002 | 0.0001 | 0.0031 | 0.0036 | 0.0008 | 0.0042 | 0.0176 | 0.0098 | 0.0025 | 0.0004 | 0.0005 | 0.0004 | 0.0044 | 0.0014 | 0.0015 |
| Bud Site | 0.0116 | 0.0003 | 0.0035 | 0 | 0 | 0.0001 | 0.01 | 0.0096 | 0.0047 | 0.0003 | 0.0037 | 0.0002 | 0.0014 | 0.0293 | 0.0007 | 0.0005 | 0.0315 | 0.0005 |
| Cell Periphery | 0.0006 | 0.0001 | 0.0001 | 0.0002 | 0 | 0.0001 | 0.0005 | 0.0001 | 0.0003 | 0.0001 | 0.0001 | 0.0001 | 0.0002 | 0.0002 | 0.0002 | 0.0002 | 0.0004 | 0.0001 |
| Cytoplasm | 0.0234 | 0.0548 | 0.0224 | 0.0263 | 0.0269 | 0.0512 | 0.0202 | 0.0106 | 0.0076 | 0.009 | 0.0102 | 0.0211 | 0.0143 | 0.0147 | 0.0126 | 0.0226 | 0.0103 | 0.0152 |
| Cytoplasmic Foci | 0.0311 | 0.004 | 0.0076 | 0.0074 | 0.0014 | 0.022 | 0.013 | 0.0022 | 0.0212 | 0.0236 | 0.0479 | 0.016 | 0.0227 | 0.0017 | 0.0041 | 0.0047 | 0.0148 | 0.0019 |
| Eisosomes | 0.002 | 0.0005 | 0.0012 | 0.0003 | 0.0002 | 0.0002 | 0.0007 | 0.0002 | 0.0004 | 0.0002 | 0.0002 | 0.0001 | 0.0008 | 0.0003 | 0.001 | 0.0002 | 0.0003 | 0.0004 |
| Endoplasmic Reticulum | 0.0012 | 0.0003 | 0.0004 | 0.0004 | 0.0001 | 0.0011 | 0.0035 | 0.0002 | 0.0012 | 0.0008 | 0.0007 | 0.0003 | 0.0039 | 0.0003 | 0.0012 | 0.0007 | 0.0002 | 0.0007 |
| Endosome | 0.0099 | 0.0004 | 0.0014 | 0.0038 | 0 | 0.0119 | 0.0057 | 0.0001 | 0.0224 | 0.0184 | 0.0327 | 0.0062 | 0.0113 | 0.0002 | 0.0055 | 0.0004 | 0.0001 | 0.0021 |
| Golgi | 0.0017 | 0.0001 | 0.0006 | 0.0001 | 0 | 0.0007 | 0.0034 | 0 | 0.0107 | 0.0045 | 0.0268 | 0.0028 | 0.0038 | 0 | 0.0015 | 0.0001 | 0.0001 | 0.0018 |
| Lipid Particles | 0.0079 | 0.0002 | 0.0044 | 0.0004 | 0.0001 | 0.0023 | 0.0127 | 0.0002 | 0.0087 | 0.0055 | 0.0115 | 0.0011 | 0.0118 | 0.0002 | 0.0023 | 0.0006 | 0.0002 | 0.0018 |
| Mitochondria | 0.003 | 0.0004 | 0.0009 | 0.0003 | 0.0001 | 0.0016 | 0.0043 | 0.0003 | 0.0048 | 0.0236 | 0.0174 | 0.0119 | 0.0025 | 0.0002 | 0.0014 | 0.0005 | 0.0002 | 0.0012 |
| None | 0.8691 | 0.9337 | 0.9403 | 0.9552 | 0.9696 | 0.8868 | 0.8674 | 0.9706 | 0.8577 | 0.8317 | 0.8015 | 0.9207 | 0.8452 | 0.9508 | 0.9271 | 0.9532 | 0.9281 | 0.9359 |
| Nuclear Periphery | 0.0016 | 0.0002 | 0.0007 | 0.0004 | 0.0001 | 0.0016 | 0.0011 | 0.0002 | 0.0034 | 0.002 | 0.0008 | 0.0005 | 0.0196 | 0.0001 | 0.0023 | 0.0008 | 0.0001 | 0.0017 |
| Nucleolus | 0.0032 | 0.0001 | 0.0008 | 0.0003 | 0.0001 | 0.0004 | 0.0008 | 0.0002 | 0.0018 | 0.0005 | 0.0003 | 0.0007 | 0.0012 | 0.0001 | 0.0005 | 0.0009 | 0.0009 | 0.0002 |
| Nucleus | 0.0027 | 0.0003 | 0.0028 | 0.0004 | 0.0002 | 0.0008 | 0.001 | 0.0004 | 0.0017 | 0.0007 | 0.0003 | 0.0008 | 0.0104 | 0.0003 | 0.0007 | 0.0016 | 0.0004 | 0.0004 |
| Peroxisomes | 0.004 | 0.0006 | 0.0029 | 0.0001 | 0.0001 | 0.001 | 0.018 | 0.0001 | 0.0066 | 0.0168 | 0.0131 | 0.0025 | 0.0068 | 0.0001 | 0.0004 | 0.0003 | 0.0004 | 0.0009 |
| Punctate Nuclear | 0.0115 | 0.0006 | 0.0045 | 0.0018 | 0.0007 | 0.0018 | 0.0023 | 0.001 | 0.0013 | 0.0006 | 0.0008 | 0.0027 | 0.0143 | 0.0002 | 0.0094 | 0.0031 | 0.0013 | 0.0009 |
| Vacuole | 0.0019 | 0.0002 | 0.0004 | 0.0019 | 0 | 0.0024 | 0.0015 | 0.0001 | 0.0043 | 0.0039 | 0.0015 | 0.0026 | 0.0008 | 0.0003 | 0.0015 | 0.001 | 0.0002 | 0.0002 |
| Vacuole Periphery | 0.0006 | 0 | 0.0001 | 0.0002 | 0 | 0.0006 | 0.0003 | 0 | 0.001 | 0.0015 | 0.001 | 0.0007 | 0.0007 | 0 | 0.0007 | 0.0002 | 0 | 0.0002 |
Sequencing Data
| R1 | R2 | |||||||||
|---|---|---|---|---|---|---|---|---|---|---|
| G1 Post-START | S/G2 | Metaphase | Anaphase | Telophase | G1 Post-START | S/G2 | Metaphase | Anaphase | Telophase | |
| Gene Expression | 104.9177 | 132.0789 | 645.9158 | 423.3903 | 74.3837 | 123.3181 | 131.9465 | 284.3048 | 266.528 | 78.2584 |
| Translational Efficiency | 1.0349 | 0.7775 | 1.0498 | 0.9738 | 1.0083 | 0.7749 | 0.9441 | 0.9816 | 0.9678 | 0.9042 |
Hit Data
| Dataset | Hit |
|---|---|
| Protein Concentration | ✘ |
| Protein Localization | ✘ |
| Gene Expression | ✔ |
| Translational Efficiency | ✘ |
Endocytosis
| Temp | Actin Patch (Sac6-tdTomato) | Cortical Patch (Sla1-GFP) | Late Endosome (Snf7-GFP) | Vacuole (Vph1-GFP) |
|---|---|---|---|---|
| 37℃ | ||||
| RT |
Cell Cycle Omics
CYCLoPs (Pho3-GFP)
| Gene / Allele | Actin Patch (Sac6-tdTomato) | Cortical Patch (Sla1-GFP) | Late Endosome (Snf7-GFP) | Vacuole (Sac6-tdTomato) |
|---|
| Gene | Images |
|---|
| Gene | Images |
|---|
Images are not yet available
Images are not yet available